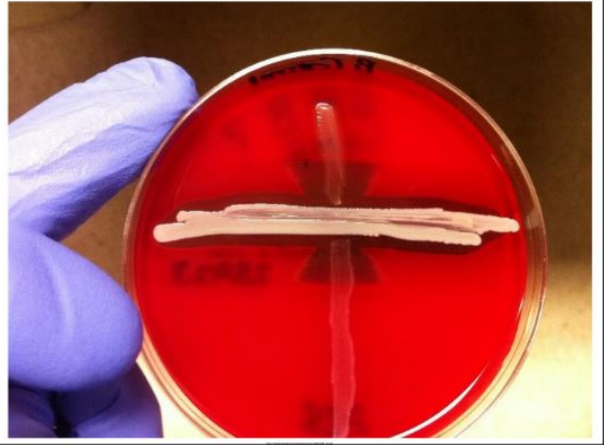
Resource image

PROCOMÚN
Showing results from 1 to 10 out of 10
-
DISOLUCIONES, DILUCIONES Y DENSIDAD
 Material explicativo sobre qué es y cómo se prepara una disolución y una dilución, acompañado de problemas sobre concentración y densidad de soluciones y disoluciones.Área de conocimientoContexto educativoTipo de recurso
Material explicativo sobre qué es y cómo se prepara una disolución y una dilución, acompañado de problemas sobre concentración y densidad de soluciones y disoluciones.Área de conocimientoContexto educativoTipo de recurso -
Equipos de laboratorio
Presentación demostrativa sobre el uso correcto de la balanza y la placa agitadora calefactora en el laboratorio. Se explicarán sus partes, funcionamiento y normas básicas de seguridad. El alumnado observará cómo se realiza el pesado exacto de sustancias y la disolución controlada mediante agitación y calentamiento. La actividad busca que comprendan la importancia de la precisión, el manejo adecuado de los equipos y la prevención de riesgos durante el trabajo experimental.Área de conocimientoContexto educativoTipo de recurso
Presentación demostrativa sobre el uso correcto de la balanza y la placa agitadora calefactora en el laboratorio. Se explicarán sus partes, funcionamiento y normas básicas de seguridad. El alumnado observará cómo se realiza el pesado exacto de sustancias y la disolución controlada mediante agitación y calentamiento. La actividad busca que comprendan la importancia de la precisión, el manejo adecuado de los equipos y la prevención de riesgos durante el trabajo experimental.Área de conocimientoContexto educativoTipo de recurso -
Disolución casera.pdf
 Se trata de realizar la disolución en casa, de modo que se realizan la investigación previa con los cálculos necesarios, la búsqueda de material óptimo para realizarla y la disolución propiamente dicha con su informe de laboratorio.Área de conocimientoContexto educativoTipo de recurso
Se trata de realizar la disolución en casa, de modo que se realizan la investigación previa con los cálculos necesarios, la búsqueda de material óptimo para realizarla y la disolución propiamente dicha con su informe de laboratorio.Área de conocimientoContexto educativoTipo de recurso -
CONCENTRACIÓN DE LAS DISOLUCIONES.pdf
 Esta infografía permite al alumnado memorizar algunas de las fórmulas usadas para expresar la concentración de las disoluciones.Área de conocimientoContexto educativoTipo de recurso
Esta infografía permite al alumnado memorizar algunas de las fórmulas usadas para expresar la concentración de las disoluciones.Área de conocimientoContexto educativoTipo de recurso -
Disoluciones
 El presente Rea nos permite adentrarnos en el mundo de las disoluciones, conocer su importancia y su uso en la vida cotidianaÁrea de conocimientoContexto educativoTipo de recurso
El presente Rea nos permite adentrarnos en el mundo de las disoluciones, conocer su importancia y su uso en la vida cotidianaÁrea de conocimientoContexto educativoTipo de recurso -
Disoluciones
 REA Las disoluciones para un alumnado comprendido entre 15 y 16 añosÁrea de conocimientoContexto educativoTipo de recurso
REA Las disoluciones para un alumnado comprendido entre 15 y 16 añosÁrea de conocimientoContexto educativoTipo de recurso -
CT1 - Práctica 4.3: Mezclas y disoluciones
 Enseñanza y Nivel: ESA I Nombre ámbito: Ámbito Científico Tecnológico Tipo tarea: Práctica Descripción: Esta tarea está relacionada con ideas y conceptos relacionados con los estados de agregación de las sustancias, mezclas y disoluciones.Contexto educativoTipo de recurso
Enseñanza y Nivel: ESA I Nombre ámbito: Ámbito Científico Tecnológico Tipo tarea: Práctica Descripción: Esta tarea está relacionada con ideas y conceptos relacionados con los estados de agregación de las sustancias, mezclas y disoluciones.Contexto educativoTipo de recurso -
BI2 - Tema 1.2: La base molecular y fisicoquímica de la vida: El agua y las sales minerales
 Curso 1º - Enseñanza Bachillerato Nombre asignatura/materia: Biología y GeologíaContexto educativoTipo de recurso
Curso 1º - Enseñanza Bachillerato Nombre asignatura/materia: Biología y GeologíaContexto educativoTipo de recurso -
Concentración y solubilidad
 - Concentración - Tipos de concentración: gramos por litro, porcentaje en masa, porcentaje en volumen - Solubilidad - Modificación de la solubilidad con la temperatura - Gráficas de solubilidadÁrea de conocimientoContexto educativoTipo de recurso
- Concentración - Tipos de concentración: gramos por litro, porcentaje en masa, porcentaje en volumen - Solubilidad - Modificación de la solubilidad con la temperatura - Gráficas de solubilidadÁrea de conocimientoContexto educativoTipo de recurso -
Sistemas Materiales
 Conocer aspectos de las sustancias y las disolucionesÁrea de conocimientoContexto educativoTipo de recurso
Conocer aspectos de las sustancias y las disolucionesÁrea de conocimientoContexto educativoTipo de recurso


